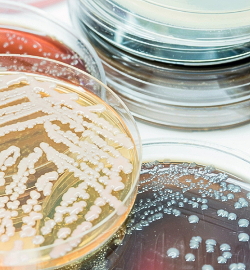

Restoration Cleaning & Remediation Services Yeppoon
Comprehensive Remediation Cleaning Services in Yeppoon
Revive Cleaning & Restoration provides a wide range of expert restoration cleaning services for commercial properties across Yeppoon. Our service areas extend throughout Central Queensland, including Rockhampton, Gladstone, Biloela, and Emerald.
Our experienced team carries out a comprehensive range of professional restoration solutions. From carpet cleaning to multi-storey water damage clean-ups – we can do it all. We also provide a dedicated 24-hour emergency cleaning service, handling a variety of cleaning related to fire, flood, storm, and smoke damage.
Cleaning, Mould Removal & Disaster Management Services In Yeppoon & Rockhampton
Revive Cleaning & Restoration offers cleaning services in Yeppoon & for all of central Queensland and surrounding areas. Our licensed team can handle any size job, ranging from simple home carpet clean to multi storied building flooded top to bottom. We also provide 24/7 assistance related to emergency water damage, drying, fire and smoke damage.
Water Damage
From flooding to burst pipes, Revive will make the difficult journey run smoothly from the beginning of water loss to the end of the restoration process. Project management ensures all water damage and structural drying, quickly and efficiently.
Our team of experts are on call 24/7 to quickly decontaminate your business if you’ve experienced pipe blockages, toilet backups, flooding caused by stormwater runoff, flood damage and more!
Being specialists in contaminated water cleanups for insurance companies or private inquiries, Revive Restorations provides reports that targets all the information required by insurance.
Carpet & Upholstery Cleaning
Revive Cleaning & Restoration is your carpet cleaning specialist in Yeppoon. We offer certified carpet cleaning to Australian standards, with our team leaving your carpets clean, fresh smelling and thoroughly decontaminated. If you are considering replacing the carpets at your home or business, give our cleaning service a try first!
Fire Damage
At Revive, we take the highest measures to complete the remediation process from fire.
All fire damage restorations are completed with the upmost care by our team of professionals, and we liaise closely with the authorities and insurance companies involved or privately engaged owners.
We have 24/7 emergency response to ensure your property the remediation process is managed quickly and smoothly.
Water Damage Restoration
We understand how water damage can be a monumental problem at homes, apartments and businesses in the area. It is why we provide a 24/7 emergency water drying service. We can handle water damaged carpets, curtains, walls, basements, buildings and other structures. We not only dry the area but also remove bacteria and odours, allowing you to return to business as usual.
Trauma & Crime Scene
Trauma Remediation is the specialised cleaning of an area or room that has been affected by a traumatic event. Revive staff prides themselves on a professional approach to sensitive situations.
Removing biohazards such as blood and other general stains from sites requires a specialised restoration process. Revive performs rectification of site residue left behind after police investigations.
Fire & Smoke Damage
Was there a fire at or near your home or business? Call Revive Cleaning & Restoration for fire and smoke damage recovery services. We clean your walls, decontaminate the area and ensure that everything looks like it did before the incident.
Mould Remediation
Revive Cleaning & Restoration leads the way in mould remediation by utilising state-of-the-art technology and advanced techniques, all while adhering to industry standards. We effectively address mould growth and its underlying causes.
Our comprehensive testing process identifies and assesses the extent of mould in your property, following IICRC guidelines to ensure we meet the highest industry standards.

Contact us today to speak with a team member and discover how we can assist you.
Structural Drying Commercial & Residential
- 24/7 Water Damage Restoration
- Timber flooring
- Wall framing & ceiling cavities
- Subfloor drying
- Thermal imaging
- Drying and Dehumidifying
- Moisture mapping
- Document Restoration
- Strip outs
Flooring & Upholstery Cleaning
Carpet, Rug & Upholstery Cleaning –
Whether your furniture needs freshening up or has sustained unsightly stains and spills, we have you covered. Our team has been providing carpet rug and furniture cleaning since 1985. With a wealth of knowledge, we provide comprehensive services to restore a wide range of rugs and upholstery coverings. We offer specialist biohazard removal services and ensure every cleaning job is completed to the highest standards.
Hard Surface Restoration –
Time, use and environment or an event can create a build-up of grime on many hard surfaces such as concrete, stone, tile, brick and pebblecrete. At Revive, we use specialised chemicals and equipment to restore hard surfaces without damaging your property.
Disaster Cleanups
Was there a tornado, hurricane, earthquake, fire, flood or another natural disaster that damaged your property? Contact Revive Cleaning & Restoration in Yeppoon, Gracemere, Rockhampton and surrounding areas for immediate assistance. We can restore your property to its original state and help you file the relevant insurance claims.
Testing & Site Readings
Revive Restoration performs testing using laboratory services for the following –
- Methamphetamine Testing of businesses
- Air sampling for Mould levels
- Tape Sampling for Mould identification
- E Coli Tape Sampling for biohazard-affected areas
- Moisture testing to identify elevated moisture readings
- Thermal Photos and videos to identify elevated moisture onsite
Mould Testing –
Revive Restoration Services uses industry-leading technology and procedures (including bio-tape and air sampling) to test and alleviate mould growth, malodours, and the underlying causes.
Ecoli Testing –
Often an event as innocent as a spilt fish tank can lead to malicious bacteria onsite- site testing for E Coli can be performed by Revive Restoration to identify if a site is affected.
Mould Remediation
Mould can wreak havoc on your property if it is allowed to linger. Mould thrives on moisture, especially in the warmer months. If you notice any signs of mould, contact Revive immediately. We are certified to decontaminate your area and remove any traces of mould before it compromises your foundation.
Methamphetamine Testing
Methamphetamine Testing for Commercial Properties –
Revive Restoration performs testing with an independent laboratory that delivers results detailing the levels found onsite. Revive Restoration staff are fully trained in methamphetamine testing. Full laboratory reports are provided with a breakdown of the results. Recommended measures required for full removal of any residue are provided on the assessment of laboratory results.
Crime Scene & Trauma Clean up
If there was a criminal incident at your property, you might be in a state of shock. Once the police finish with their work, you may contact Revive for professional cleanup services. We can remove crime scene residues, bloodborne pathogens, severe stains and any other blemishes that trace back to the incident.
Methamphetamine Restoration
It is a common misconception that a property can only be contaminated through the manufacturing stage—smoking and usage of the substance can cause contamination too. Chemical residue can be retained in soft furnishings, carpets, timber floors, door frames, walls and ceilings, causing a risk to residents via air or dermal transfer.
The health impacts of residue onsite are very serious. If you suspect there is a potential for residue, testing should be completed as a matter of urgency. Revive provides testing and will compile an independent laboratory report for you, including a breakdown of test results and relevant information.
Fortunately, we have the means to give you peace of mind regarding your property’s possible contamination levels and if detected, a remediation action plan to ensure your property is restored and once again safe for occupation.
Large Loss Restoration
Revive Restorations has the equipment and specialised staff needed to accommodate large losses in commercial properties. Revive Restorations provide restoration to the highest standard and accommodate a large loss with the efficacy required to get businesses back to pre-loss condition quickly.
With speedy and professional response, the team can assist with any Large Loss incident.
Contact us today to learn more about our process.
Our Equipment
Revive Restorations stays up to date with the latest most efficient equipment. We stock a large quantity of restoration equipment to accommodate large losses for commercial properties.
Our equipment is suited for restoration cleaning services across a wide range of industries.
Frequently Asked Questions
Do You Bring Your Own Cleaning Equipment And Supplies?
Yes, we bring all our cleaning equipment with us. This means you don’t have to worry about buying supplies or freeing up storage space. We use quality supplies too, so rest assured you'll get high-quality results.
Do You Provide Cleaning Services For Communal Areas?
Yes, we’re more than happy to schedule a time to clean shared staircases, halls, and main doors.
Can I Give Feedback After Using Your Cleaning Services?
Of course. Our commitment to customer satisfaction is at the heart of what we do here at Revive Cleaning & Restoration. For this reason, we’d be delighted to hear your feedback about our services via phone, email, social media, or letter.
Do I Need To Be Present During The Cleaning Service?
While you can stay during the service, it’s not necessary. We have a security system in place to protect your keys and alarm codes, so you don’t have to think twice about the safety of your business.
What Are The Prices Of Your Cleaning Services?
The cost of each cleaning service will differ due to several factors, like the nature of the cleaning job, the time it would take to complete, and the size of the property to be cleaned. We’re pleased to say, however, that at Revive Cleaning & Restoration, we offer cleaning services at competitive prices. Call us today for a quote.
Contact Us Today
Don’t hesitate to contact Revive Cleaning & Restoration for all your cleaning needs. Give our professional and expert team a call on 07 4938 7377.
Methamphetamine testing & decontamination
Does your business require quick and efficient lab tests for specific drugs? Allow Revive Cleaning & Restoration to assist you in testing your employees affordably in Yeppoon, Gracemere, Rockhampton and surrounding areas.